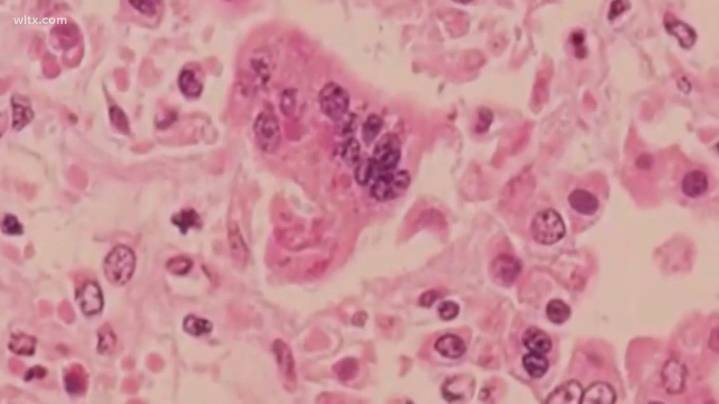

SPARTANBURG COUNTY, S.C. — An ongoing measles outbreak in the Upstate has led to two more cases in South Carolina, state health officials confirm.
The South Carolina Department of Public Health announced on Tuesday that the number of measles cases linked to a Spartanburg County outbreak has increased to seven, bringing the state's total for 2025 to 10. The agency reports that one of the other cases, not tied to the current outbreak, also occurred in Spartanburg County.
So far, some cases in the state have been linked to travel and close contact with known infected people. However, the outbreak has no identified source, suggesting that the virus is circulating in the community, meaning the number of cases may be higher.
Measles is highly contagious, infecting nine out of 10 people who ar

 News 19 WLTX
News 19 WLTX
WYFF Greenvile
WYFF Greenvile WIS News 10 South Carolina
WIS News 10 South Carolina WSPA 7News
WSPA 7News AlterNet
AlterNet Health Digest
Health Digest The Conversation
The Conversation WTAJ-TV
WTAJ-TV Vogue Beauty
Vogue Beauty WBTV Mecklenburg County
WBTV Mecklenburg County Healthcare Dive
Healthcare Dive New York Post Health
New York Post Health RadarOnline
RadarOnline